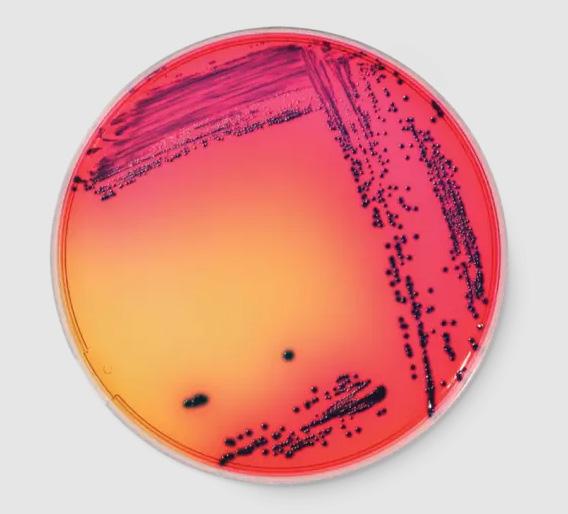

NYHEDSBREV 2026

FOOD SAFETY & DIAGNOSTI CS
Din partner i fødevaresikkerhed
Side: 2-3. E.Coli, de fredelige og de farlige.
Side: 4-5. Hygicult
Side: 6-7. CDR Foodlab: For olie og fedt
E.coli – de fredelige og de farlige
•Escherichia coli (E. coli) er en bakterie, der almindeligvis findes i tyktarmen hos varmblodede organismer. De fleste E.coli-stammer er harmløse, men nogle kan forårsage alvorlig madforgiftning.
•Shigatoksin-producerende E. coli (STEC) er bakterier, der kan forårsage alvorlig fødevarebåren sygdom.

• Primære kilder til STEC-udbrud er rå eller underkogte hakkede kødprodukter, rå mælk og fækal forurening af grøntsager.
• STEC kan vokse ved en temperatur mellem 7 og 50 °C med optimum ved 37 °C, de kan overleve pH ned til 4,4 og aw ned til 0,95. STEC bliver dræbt ved en tilberedning af mad på 70 °C eller derover.
I de fleste tilfælde er sygdommen selvbegrænsende, men den kan føre til livstruende sygdom, herunder hæmolytisk uræmisk syndrom (HUS), især hos små børn og ældre.
Der findes mange undertyper af E. coli STEC, men nogle af de mest kendte er:
1. E. coli 0157
Den mest kendte og hyppigste årsag til alvorlige udbrud.
Kan forårsage blodig diarré og i alvorlige tilfælde nyresvigt
2. E. coli O26
Ligner O157, men er mindre kendt.
Kan også forårsage blodig diarré og alvorlige komplikationer.
3. E. coli 0111
En anden farlig undertype. Kan føre til alvorlige infektioner og udbrud.
4. E. coli 045, 0103, 0121, 0145
Andre undertyper, der også kan forårsage sygdom. Ikke så kendte som O157, men stadig farlige.
SHIGATOXIN (STX)
STEC kan have forskellige virulensfaktorer, som bidrager til deres evne til at forårsage sygdom. To vigtige virulensfaktorer er stx (Shiga-toksin) og eae (intimin).

stx generne koder for produktionen af Shiga-toksiner, som er potentielt farlige proteiner.
•Disse toksiner kan skade cellerne i tarmslimhinden, hvilket fører til blodig diarré.
•Der findes to hovedtyper af Shiga-toksiner: Stx1 og Stx2 , hvoraf Stx2 generelt anses for at være mere potent og mere forbundet med alvorlige komplikationer som hæmolytisk uræmisk syndrom (HUS).
INTIMIN (eae)
• eae genet koder for et protein kaldet intimin.
• intimin hjælper bakterien med at binde sig til tarmcellerne, hvilket gør det muligt for den at kolonisere tarmene.
•Dette fører til dannelse af såkaldte "attaching and effacing" læsioner, hvor bakterien sidder fast på tarmoverfladen og forårsager skade på tarmcellernes struktur.
SAMLET SET
•stx og eae er centrale for, hvordan STEC-bakterier forårsager sygdom.
•Tilstedeværelsen af begge gener i en STEC-stamme øger risikoen for alvorlige sygdomsforløb.
•For at beskytte sig mod STEC-infektioner er det vigtigt at praktisere god hygiejne og holde styr på fødevaresikkerheden
ANALYSMETODER
Vi anbefaler som udgangspunkt to forskellige måder at detektere E.coli på. Det gælder både de fredelige og de farlige.
•Chromogene medier: Chromogene medier er alternativer til de gængse metoder. De er typisk enklere og hurtigere at bruge. De er naturligvis også validerede. RAPID E.coli O157:H7 af AOAC og Afnor, RAPID E.coli2 desuden af Health Canada og Nordval.
•Real time PCR: når det gælder STEC, vil de fleste vælge at bruge rt-PCR. Det giver, i modsætning til traditionelle/chromogene plader, mulighed for, enten at identificere hvilken specifik serotype det drejer sig om, eller at identificere virulensfaktorerne. Begge dele kan være vigtigt i forhold til udvikling af sygdom.
Antallet af mennesker, som er blevet syge af STEC i DK, er i de sidste 25 år gået fra nærmest ingen til over 600/år. Der er pt. kun grænseværdi for STEC i spirer, selvom kød (specielt hakket kød) i en del tilfælde har været mistænkt som smittekilden. Det første udbrud på verdensplan var med serotypen O157:H7 netop i hakket kød, derfor har denne nu “kælenavnet” burgerbakterien.

Hygicult - fordi kvalitet er vigtig.
Er dine overfladetests NordVal-certificerede?
Hvis dine tests er af dårlig kvalitet, får du altid dårlige testresultater – du kan ikke regne med dem. Der er ingen grund til at løbe unødvendige risici for produkttilbagekaldelser eller ubehagelige overraskelser for kunderne.
Du kan spare tid og bekymringer ved at bruge det rigtige produkt og vide at du har helt styr på hygiejnen.
Hygicult kontaktplader er beregnet til pålidelig og tidsbesparende monitorering af mikrobiologisk hygiejne på stedet. Hygicult kan også anvendes som transportmedie, hvis der er brug for yderligere analyse af prøverne.
Dip-slides anvendes i fødevareindustri, storkøkkener, delikatesseafdelinger, food trucks, hospitaler, vaskerier, rengøringsbranchen osv. og er særligt anvendelig at bruge til egenkontrol af både overflader, når der ikke er laboratoriefaciliteter til stede.
Hvorfor foretrækker kunderne Hygicult, fremfor andre dipslides?
Nogle grunde er mere lavpraktiske end andre, men her er nogle bud:
•Hver variant Hygicult har sin egen farve låg
•Plast-delen er sort, hvilket gør det nemt at aflæse Hygicult
•Hygicult er robust og taber ikke agaren
•Der medfølger et aflæsningskort med estimerede værdier
•Flere af varianterne er NordVal-certificeret og/eller AOAC-valideret


Pålidelig
Etableret metode med lang erfaring
• AOAC-validerede metoder
Certificeret af NKML/NordVal
Brugervenlig
Tre nemme trin: prøve-Inkubere-fortolke
• Hængslet plade til prøvetagning fra overflader
Certificeret af NKML/NordVal
• Ingen optælling af kolonier Ingen mikrobiologiske færdigheder kræves
1-2-3
Fleksibel
• Lang holdbarhed
Opbevaring ved stuetemperatur
• Inkubation ved omgivende temperatur eller
inkubator
Anvendelse
• Restaurant og cateringtjenester
Fremstilling af drikkevarer
• Hospitaler og sundhedsområder
• Private hjem og dagplejeområde
Vaskerier og tekstiltjenester
• Indendørssvømmebassiner og spafaciliteter
Motions- og fitnesscentre
• Skønhedsklinikker og tatoveringsbutikker
• Fremstilling af kosmetik
• Anlæg til fødevareproduktion: bagerier, mejerier, slagterier, fabrikker til forabejdning af fisk
CDR FoodLab ® for olie & fedt
Intuitivt, præcist og pålideligt:
CDR FOODLab®
CDR FoodLab® fungerer som et analyselaboratorium. Det er udviklet til at udføre nemme og hurtige kemiske analyser direkte på produktionslinjen eller i laboratoriet, uden personale med erfaring i titreringer.
CDR FoodLab® optimerer traditionelle testmetoder, hvilket gør dem hurtigere og lettere, samtidig med at det dog sikres at standarderne overholdes i forhold til ISO-referencemetoderne.

CDR FoodLab® fungerer til analyse på alle slags vegetabilske olier, men også animalsk fedt kan uden problemer analyseres på instrumentet.
Der er ikke krav til kalibrering. Der kan dog udtrækkes filer fra instrumentet så producenten har mulighed for at kontrollere at det kører og fungerer optimalt. Derudover findes der standard opløsninger til de fleste analyser, så man har mulighed for at kontrollere at testene udføres korrekt.
Med CDR FoodLab® for oils and fats er det muligt at analysere for: frie fedtsyrer, peroxidtal, anisidintal, iodtal og forsæbningstal. Og som noget helt nyt: mængden af sukker i de kartofler, der bruges til pommes frites og chips.
Og med CDR FoodLab® sparer du tid og minimerer forbruget af både kemikalier og plastvarer.
Instrumentet er kompakt og praktisk og består af: en analyseenhed med fotometer baseret på LED-teknologi og kits med pre-fyldte kuvetter klar til brug. Reagenserne der specifikt er udviklet af CDR’s laboratorium har lav toksicitet og specialpipetter, der gør det muligt at afpipettere den korrekte prøvevolumen.


Hvorfor er det så vigtigt at kende sukkerindholdet i kartofler?
Sukkerindholdet i kartofler er vigtigt, når de skal frituresteges, på grund af den kemiske reaktion kendt som Maillard-reaktionen.

1. Maillard-reaktionen: Denne reaktion sker mellem aminosyrer og reducerende sukkerarter ved høje temperaturer og er ansvarlig for bruningen og udviklingen af smag i mange stegte fødevarer. Hvis kartofler har et højt sukkerindhold, vil de brune hurtigere og udvikle en rigere smag og farve.
2. Farve: Kartofler med højere sukkerindhold kan blive meget mørke eller endda brændte under friturestegning. Dette kan føre til en uønsket mørk farve og potentielt en brændt smag.
3. Smag: Sukkerindholdet påvirker smagen. Mens en vis bruningsgrad er ønskværdig for at give pommes frites eller andre friturestegte kartofler en god smag, kan for meget sukker resultere i en bitter eller brændt smag.
4. Konsistens: Sukkerindholdet kan også påvirke kartoflernes konsistens. Kartofler med lavt sukkerindhold har tendens til at blive sprødere, hvilket er ønskeligt for mange friturestegte kartoffelretter som pommes frites.

Af disse grunde forsøger man ofte at kontrollere og justere sukkerindholdet i kartofler, der er beregnet til friturestegning. For eksempel kan kartofler lagres ved lave temperaturer (men ikke for lave, da det kan øge sukkerindholdet) og behandles på måder, der hjælper med at balancere sukkerindholdet for at opnå den ønskede farve, smag og konsistens.
Med CDR FoodLab® for oils and fats er det nemt og hurtigt at få en præcis værdi for både glukose og fruktose separat og totalt i måleområdet 5-2500 mg/kg.

Dyr med kulørt blod i årerne
Biokemi
Danmark
Cristiana@foodiagnostics.dk Telefon: 2594 8086
Færøerne
Det meste af det, vi ser i naturen, bløder rødt, fordi vi er vant til hvirveldyr med jernholdigt hæmoglobin. Men dyreriget gemmer på en fascinerende palette af alternative farver, når det kommer til det livgivende blod. Mange bløddyr og leddyr, som f.eks. blæksprutter, hestesko-krabber og hummere, har blåt blod.
•Hvorfor? Deres blod bruger proteinet hæmocyanin til at transportere ilt. Hvor vores blod bruger jern (som ruster og bliver rødt), bruger de kobber. Når kobberet binder sig til ilt, skifter det farve til en dyb blå.
gør vores blå mærker grønne). Normalt er stoffet giftigt, men disse øgler har så store mængder af det, at det overskygger det røde hæmoglobin. Nogle få marine hvirvelløse dyr og og visse armfødder, har lilla blod.

Runi Nielsen Tonny NielEhsan Mirsharghi Mikrobiologi
Runi@foodiagnostics.dk Telefon: (298) 591667
Danmark
•Fordelen: Hæmocyanin fungerer bedre end hæmoglobin i kolde omgivelser med lavt iltindhold, hvilket gør det perfekt til dybhavets beboere. Grønt blod findes hos visse typer af marine børsteorme og en helt særlig gruppe af øgler fra Ny Guinea.
•Marine orme: De bruger proteinet chlorocruorin. Det minder meget om vores hæmoglobin, men i en let modificeret form, der gør blodet lysegrønt, når det er iltet (og mørkegrønt i de-iltet tilstand).
•Prasinohaema-øglerne: Disse skinker har grønt blod af en helt anden årsag. Deres blod er fyldt med et affaldsstof kaldet biliverdin (det samme stof, der

Hygiejne & ECA
Danmark
Tonny@foodiagnostics.dk Telefon: 4056 5659
Ehsan@foodiagnostics.dk Telefon: 2222 7592
•Hvorfor? De bruger proteinet hæmerythrin. Når blodet ikke har ilt, er det gennemsigtigt, men så snart det binder sig til ilt, skifter det til en intens violet eller lilla farve. Det er dog ikke særlig effektivt til ilttransport sammenlignet med de andre typer. Mange insekter har hverken rødt, blåt, lilla eller grønt blod. Deres væske kaldes hæmolymfe.
•Hvorfor? Da insekter trækker vejret gennem små rør i kroppen (trakeer), behøver deres blod ikke at transportere ilt. Derfor mangler de ofte farvepigmenter helt. Det kan dog fremstå gulligt eller bleggrønt på grund af den mad, de spiser.
Farven på blodet er aldrig tilfældig. Det handler om kemi og overlevelse. Om det er kobber i det iskolde hav eller jern på savannen, har naturen fundet den præcis rigtige "opskrift" på liv, der passer til miljøet.


Justering af fragt- og miljøbidrag pr. 1. februar 2026
For at imødekomme de stigende fragtpriser samt højere omkostninger til emballage og miljøafgifter regulerer vi vores fragt- og miljøbidrag. Fra 1. februar 2026 stiger gebyret fra 150 kr. til 175 kr.
Dette sikrer, at vi fortsat kan levere den kvalitet og service, du kender os for.

Vi byder velkommen til vores to nye produktspecialister!
Vi er glade for at kunne præsentere to stærke profiler, der fremover vil styrke vores team og sikre endnu bedre support til vores kunder:
Dennis– Har solid erfaring inden for hygiejnekontrol og vil primært fokusere på hygiejne gruppen.
Anita – Bringer ekspertise inden for Biokemi og vil være jeres go-to person for teknisk rådgivning og implementering af nye metoder.
KONTAKT
Food Diagnostics A/S
Søndre Kajgade 7-9
8500 Grenaa
Danmark
Tlf: 8759 1666
Mail: info@fooddiagnostics.dk
På www.fooddiagnostics.dk og tilmeld dig vores digitale nyhedsbrev eller ’’følg’’ os på Facebook, Linkedln eller YouTube




